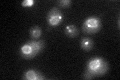
YPR174C

View description
Protein of unknown function; green fluorescent protein (GFP)-fusion protein localizes to the nuclear periphery; potential Cdc28p substrate
Localization:
Intensity:
Fold change:
Significance:
-
C’ GFP library in SD

nuclear periphery32.22 -
N' NOP1pr-GFP in SD

punctate,nuclear periphery60.912 -
N' TEF2pr-mCherry in SD

cell periphery,vacuoleN/A -
N' NATIVEpr-GFP in SD

nuclear periphery23.6925 -
N' TEF2pr-VC and Cyto-VN in SD

#N/A0 -
C’ GFP library in SD+DTT
punctate, nuclear periphery29.660.92No -
C’ GFP library in SD+H2O2

punctate, nuclear peripheryN/AN/ANo -
C’ GFP library in Starvation Media

punctateN/AN/AYes -
C’ GFP library on the background of Pup2-DaMP

nuclear periphery -
C’ GFP library on the background of CCT mutant

nuclear periphery31.51610.977988No
